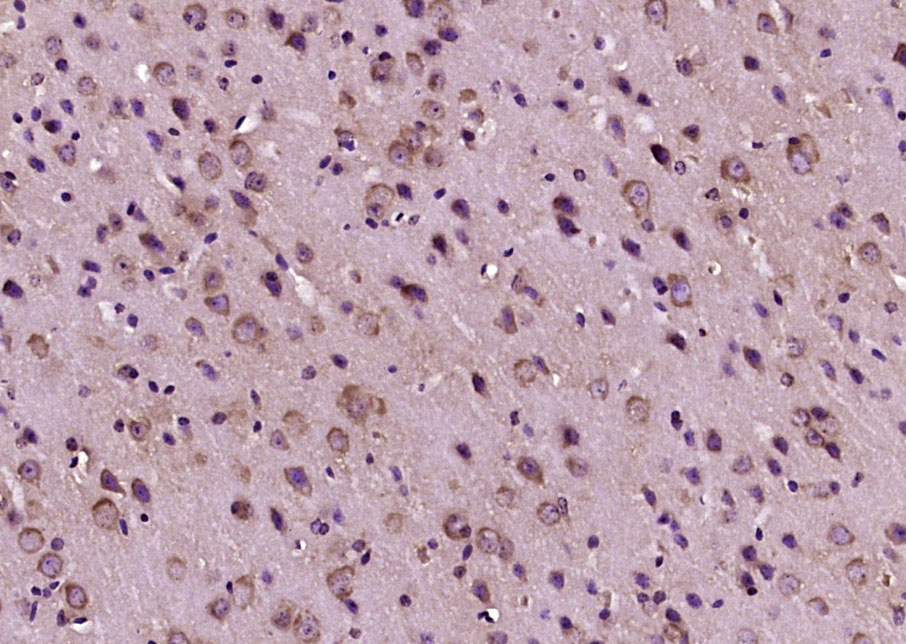
产品细节图片1

相关产品推荐更多 >
万千商家帮你免费找货
0 人在求购买到急需产品
- 详细信息
- 文献和实验
- 技术资料
- 应用范围:
产品信息以Bioss网站为准
- 规格:
50ul/100ul/200ul
| 规格: | 50ul | 产品价格: | ¥1180.0 |
|---|---|---|---|
| 规格: | 100ul | 产品价格: | ¥1980.0 |
| 规格: | 200ul | 产品价格: | ¥2800.0 |
| 产品编号 | bs-18210R |
| 英文名称 | Calcitonin Rabbit pAb |
| 中文名称 | 降钙素抗体 |
| 英文别名 | alpha CGRP; CALC 1; CALC A; CALC1; CALCA; Calcitonin related polypeptide alpha; CGRP 1; CGRP; CGRP I; CGRP-1; CGRPI; CGRP1; CT; Katacalcin; KC; MGC126648; alpha type CGRP; calcitonin 1; calcitonin gene related peptide 1; calcitonin gene related peptide I; calcitonin isoform CT preproprotein. |
| 产品应用 | WB=1:500-2000, IHC-P=1:100-500, IHC-F=1:100-500, IF=1:100-500 Not yet tested in other applications. |
| 交叉反应 | Mouse (Human, Rat, Dog, Rabbit, GuineaPig) |
| 抗体来源 | Rabbit |
| 免疫原 | KLH conjugated synthetic peptide derived from human Calcitonin |
| 亚型 | IgG |
| 性状 | Liquid |
| 纯化方法 | affinity purified by Protein A |
| 克隆类型 | Polyclonal |
| 理论分子量 | 3.5/13 kDa |
| 浓度 | 1mg/ml |
| 储存液 | 0.01M TBS (pH7.4) with 1% BSA, 0.02% Proclin300 and 50% Glycerol. |
| 研究领域 | Cancer > Growth factors > Hormones Cancer > Tumor biomarkers > Hormones Signal Transduction > Growth Factors/Hormones > Hormones |
| 亚细胞定位 | Secreted. |
| 相似性 | Belongs to the calcitonin family. |
| 功能 | The level of procalcitonin in the blood stream of healthy individuals is below the limit of detection (0.01 µg/L) of clinical assays. The level of procalcitonin rises in a response to a proinflammatory stimulus, especially of bacterial origin. It does not rise significantly with viral or non-infectious inflammations. With the derangements that a severe infection with an associated systemic response brings, the blood levels of procalcitonin may rise to 100 µg/L. In serum, procalcitonin has a half-life of 25 to 30 hours. Remarkably the high procalcitonin levels produced during infections are not followed by a parallel increase in calcitonin or a decrease in serum calcium levels. |
| 保存条件 | Shipped at 4℃. Store at -20℃ for one year. Avoid repeated freeze/thaw cycles. |
| 注意事项 | This product as supplied is intended for research use only, not for use in human, therapeutic or diagnostic applications. |
| 背景资料 | Procalcitonin (PCT) is a peptide precursor of the hormone calcitonin, the latter being involved with calcium homeostasis. It arises once preprocalcitonin is cleaved by endopeptidase. It is composed of 116 amino acids and is produced by parafollicular cells (C cells) of the thyroid and by the neuroendocrine cells of the lung and the intestine. |
| 应用 | 推荐稀释比例 |
| {WB} | {1:500-2000} |
| {IHC-P} | {1:100-500} |
| {IHC-F} | {1:100-500} |
| {IF} | {1:100-500} |

Cerebrum (Mouse) Lysate at 40 ug
Primary: Anti-Calcitonin (bs-18210R) at 1/1000 dilution
Secondary: IRDye800CW Goat Anti-Rabbit IgG at 1/20000 dilution
Predicted band size: 3.5/13 kD
Observed band size: 17 kD
风险提示:丁香通仅作为第三方平台,为商家信息发布提供平台空间。用户咨询产品时请注意保护个人信息及财产安全,合理判断,谨慎选购商品,商家和用户对交易行为负责。对于医疗器械类产品,请先查证核实企业经营资质和医疗器械产品注册证情况。
文献和实验[IF={{ 7.3 }}] {Aida Maddahi. et al. Sex differences in expression of CGRP family of receptors and ligands in the rat trigeminal system. J HEADACHE PAIN. 2024 Nov;25(1):193} {IHC} {Rat}
[IF={{ 4.132 }}] {Xiang, Chengyu. et al. Fasudil Ameliorates Osteoporosis Following Myocardial Infarction by Regulating Cardiac Calcitonin Secretion. J CARDIOVASC TRANSL. 2022 May;:1-14} {IHC} {Mouse}
[IF={{ 1.834 }}] {Fang Dai. et al. Effects of long term diabetogenic high fat diet on bone in ovariectomized female rats. BIOTECH HISTOCHEM. 2022 Jun 28} {IHC} {Rat}
Characterization of CGRP Receptor Binding
Chatterjee, T.K. and Fisher, R.A. 1991. Multiple affinity forms of the calcitonin gene‐related peptide receptor in rat cerebellum. Mol. Pharmacol. 39:798‐804. Choksi, T
= NAL), appears to form upon oxidative cyclization of the nonfluorescent 2:1 lysine-HNE Michael adduct-Schiff base cross-link (Scheme 1). Polyclonal antibody (PAb) to the NAL-HNE fluorophore was raised in rabbit and found to be highly specific
GE Healthcare Benzamidine Sepharose™ 6B is p-aminobenzamidine covalently attached to Sepharose 6B by the epoxy coupling method. p-Aminobenzamidine (PAB), is a synthetic inhibitor of trypsin-like serine protease. Trypsin and trypsin
技术资料暂无技术资料 索取技术资料







